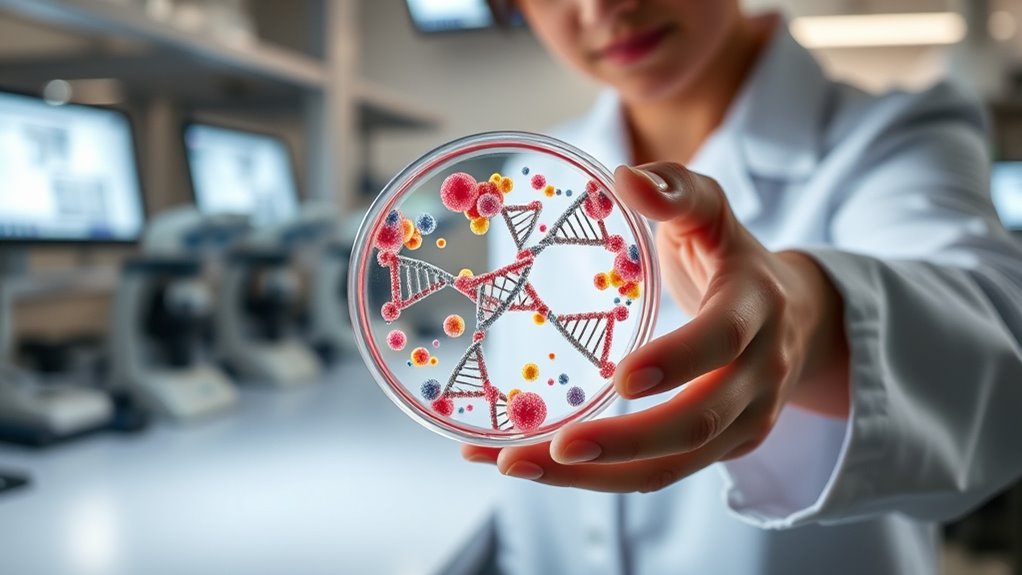
gene editing offers hope

Gene therapy is transforming how sickle cell disease is treated, using advanced techniques like CRISPR and personalized stem cell therapies. These approaches can correct genetic mutations and restore normal hemoglobin function, resulting in longer-lasting treatment effects. Clinical trials are already showing promise, suggesting that these therapies could markedly improve patient outcomes. With ongoing research, hope continues to grow for new and effective options. There’s much more to discover about these emerging treatments and their potential impact on patients.
Key Takeaways
- Gene therapy is emerging as a promising treatment for sickle cell disease, targeting the genetic roots of the condition.
- CRISPR techniques enable precise gene modifications to correct mutations causing sickle cell disease.
- Stem cell approaches involve using a patient’s modified stem cells to restore normal hemoglobin function.
- Clinical trials are showing encouraging results, indicating these therapies could soon be viable treatment options.
- Ongoing research and advancements aim to improve patient outcomes and access to these groundbreaking therapies.
As researchers continue to open the potential of gene therapy, hope is rising for those affected by sickle cell disease. You might be wondering how these advancements could change the lives of patients battling this chronic condition. The exciting developments in gene therapy, particularly through CRISPR techniques and stem cell approaches, are making waves in the medical community and offering new possibilities for treatment.
CRISPR techniques are revolutionizing the way scientists think about gene editing. By allowing precise modifications to specific genes, CRISPR opens up a world of potential for correcting the genetic mutations that cause sickle cell disease. Imagine being able to directly target the faulty gene responsible for producing abnormal hemoglobin and effectively restoring normal function. This isn’t just a fantasy; researchers are making strides in applying these techniques in clinical settings. When you consider the implications, it’s hard not to feel a surge of optimism.
CRISPR is transforming gene editing, offering hope to correct the mutations behind sickle cell disease and restore normal hemoglobin function.
Stem cell approaches also play a essential role in the quest for effective treatments. By utilizing a patient’s own stem cells, scientists can create a personalized treatment plan. This process typically involves collecting healthy stem cells from the patient, modifying them to correct the genetic mutation, and then reintroducing them into the body. With this method, you’re not only targeting the root cause of the disease but also potentially providing a long-lasting solution. This could mean a significant reduction in the painful crises associated with sickle cell disease, allowing many to enjoy a better quality of life.
While these therapies are still in development, clinical trials are already showing promising results. As you follow the progress, it’s essential to understand that these treatments could soon become viable options for many patients. The road to widespread approval may take time, but the advancements being made are nothing short of groundbreaking. You might find comfort in knowing that researchers are dedicated to pushing boundaries and finding solutions for those dealing with sickle cell disease. Practical tools can aid in navigating the complexities of medical advancements and understanding treatment options.
Frequently Asked Questions
What Is the Cost of Gene Therapy for Sickle Cell Disease?
The cost of gene therapy for sickle cell disease can be quite high, often exceeding several hundred thousand dollars per treatment. When considering a cost comparison, it’s important to check your insurance coverage, as policies vary widely. Some plans may cover a portion of the therapy, while others might not. Make sure you discuss potential costs with your healthcare provider and insurance company to understand your financial responsibilities before proceeding.
How Long Does Gene Therapy Treatment Take?
The treatment duration for gene therapy typically spans several weeks to months, depending on the specific procedure timeline. Initially, you’ll undergo pre-treatment assessments, followed by the actual gene therapy, which might take a few days in a clinical setting. Afterward, you’ll need time for recovery and monitoring. Overall, it is crucial to stay in close contact with your healthcare team to understand the exact duration and what to expect throughout the process.
Are There Any Long-Term Side Effects of Gene Therapy?
Yes, there can be long-term side effects of gene therapy. While many patients experience positive outcomes, it’s important to consider the long-term safety and potential risks involved. Some individuals may face immune reactions, unintended genetic changes, or issues related to the delivery method. Monitoring is essential, so staying in touch with your healthcare team ensures you’re aware of any developments. Always discuss any concerns you might have about long-term effects with your doctor.
Is Gene Therapy a Permanent Solution for Sickle Cell Disease?
Gene therapy offers a promising approach, but it isn’t guaranteed to be a permanent solution for sickle cell disease. While it aims for genetic permanence, the treatment’s durability can vary among individuals. Some patients may experience long-lasting benefits, while others might need additional interventions. It’s essential to monitor your health continuously and discuss potential outcomes with your healthcare provider to understand how this innovative treatment could work specifically for you.
Who Is Eligible for Gene Therapy Treatment?
To be eligible for gene therapy treatment, you generally need to meet specific patient eligibility criteria. Typically, candidates are those with a confirmed diagnosis of sickle cell disease, who are experiencing severe symptoms or complications. Your age, overall health, and previous treatments may also influence eligibility. It’s essential to consult with a healthcare provider to determine if you meet these treatment criteria and to discuss potential risks and benefits tailored to your situation.
Conclusion
So, envision this: you’re a superhero, cape flapping in the wind, battling sickle cell disease with gene therapy as your trusty sidekick. While traditional treatments are like trying to fix a leaky faucet with duct tape, gene therapy swoops in like a high-tech plumber, actually fixing the root problem. As these treatments evolve, you might just find yourself trading in that cape for a dance floor—because who needs to fight when you can groove?










